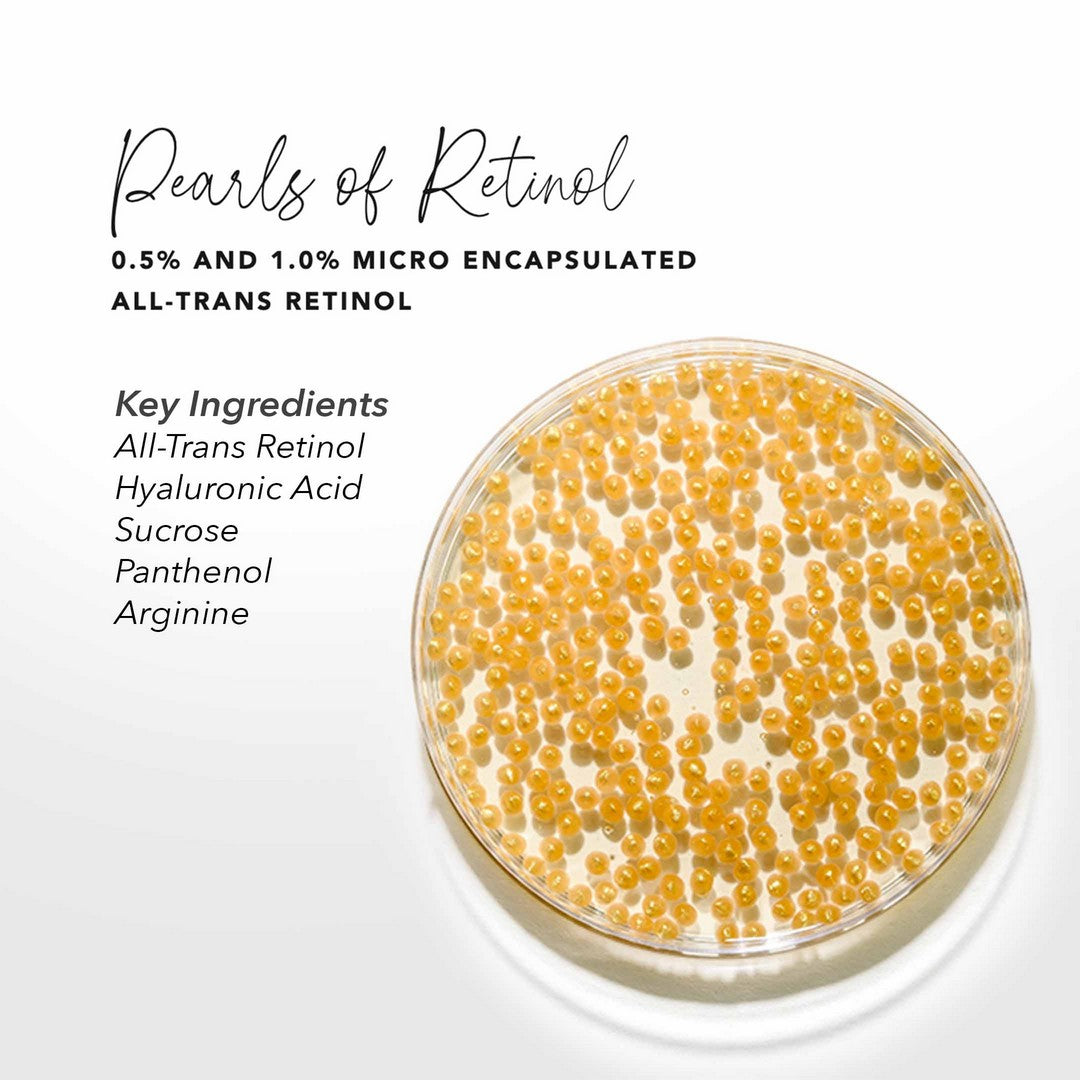

PM • All Skin Types
Pearls of Retinol
Pearls of Retinol
Regular price
$128.00 USD
Regular price
Sale price
$128.00 USD
Unit price
per
Description
Slow-Release All-Trans Retinol Serum
Created for sensitive skin, this formula features slow-release micro-encapsulated All-Trans Retinol “pearls” for gentle, low-irritation delivery. It helps visibly reduce dark spots and discoloration, promoting a brighter, more even skin tone. Enriched with ultra-hydrating ingredients, it balances texture, elasticity, and vibrance for a smoother, healthier-looking complexion.
Paraben-free
Dermatologist tested
Non-comedogenic
Cruelty-free
Fragrance-free
Gluten-free
Vegan

Related Products
Complete your skincare lineup with these complementary products, carefully curated to enhance your routine and deliver optimal results.